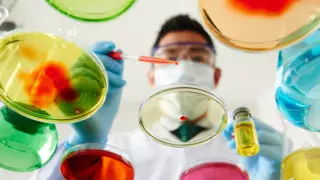
В Китае подтвержден 571 случай заражения смертельным вирусом

Как можно заразиться коронавирусной инфекцией, рассказал главый санврач, заместитель главы Комитета контроля качества и безопасности товаров и услуг Министерства здравоохранения Жандарбек Бекшин, передает корреспондент Tengrinews.kz.
"Если неделю назад мы не подтверждали передачу от человека к человеку, то, по последнему заявлению, передача от человека к человеку уже установлена. Но уровень передачи низкий и зависит от концентрации вируса, которую получает человек. В связи с тем, что идет вынос за пределы Китая в Японию, Таиланд, США, Тайвань, мы усилили дистанционный термометрический контроль всех прибывающих из КНР", - сообщил главный санврач Жандарбек Бекшин.
Он отметил, что ситуация нарастает, уже зарегистрирован 571 случай заболевания (в Китае), из них 17 случаев закончились летальным исходом.
"Мы на круглосуточном доступе с ВОЗ, постоянно мониторим ситуацию. На сегодня источники говорят, но пока не в утвердительном порядке, что причиной заболевания являются животные. Это летучие мыши, белуха, кролики, птица, дикая кошка, медвежьи лапы, медвежий и барсучий жир", - сказал Бекшин.
По его словам, основные симптомы коронавируса - это повышение температуры, слабость, одышка и кашель. Если выявляются такие пассажиры в аэропортах, то информация о них должна передаваться наземным службам.
Казахстанцев просят соблюдать "этикет кашля" и воздержаться от поездок в Китай из-за эпидемиологической ситуации.
